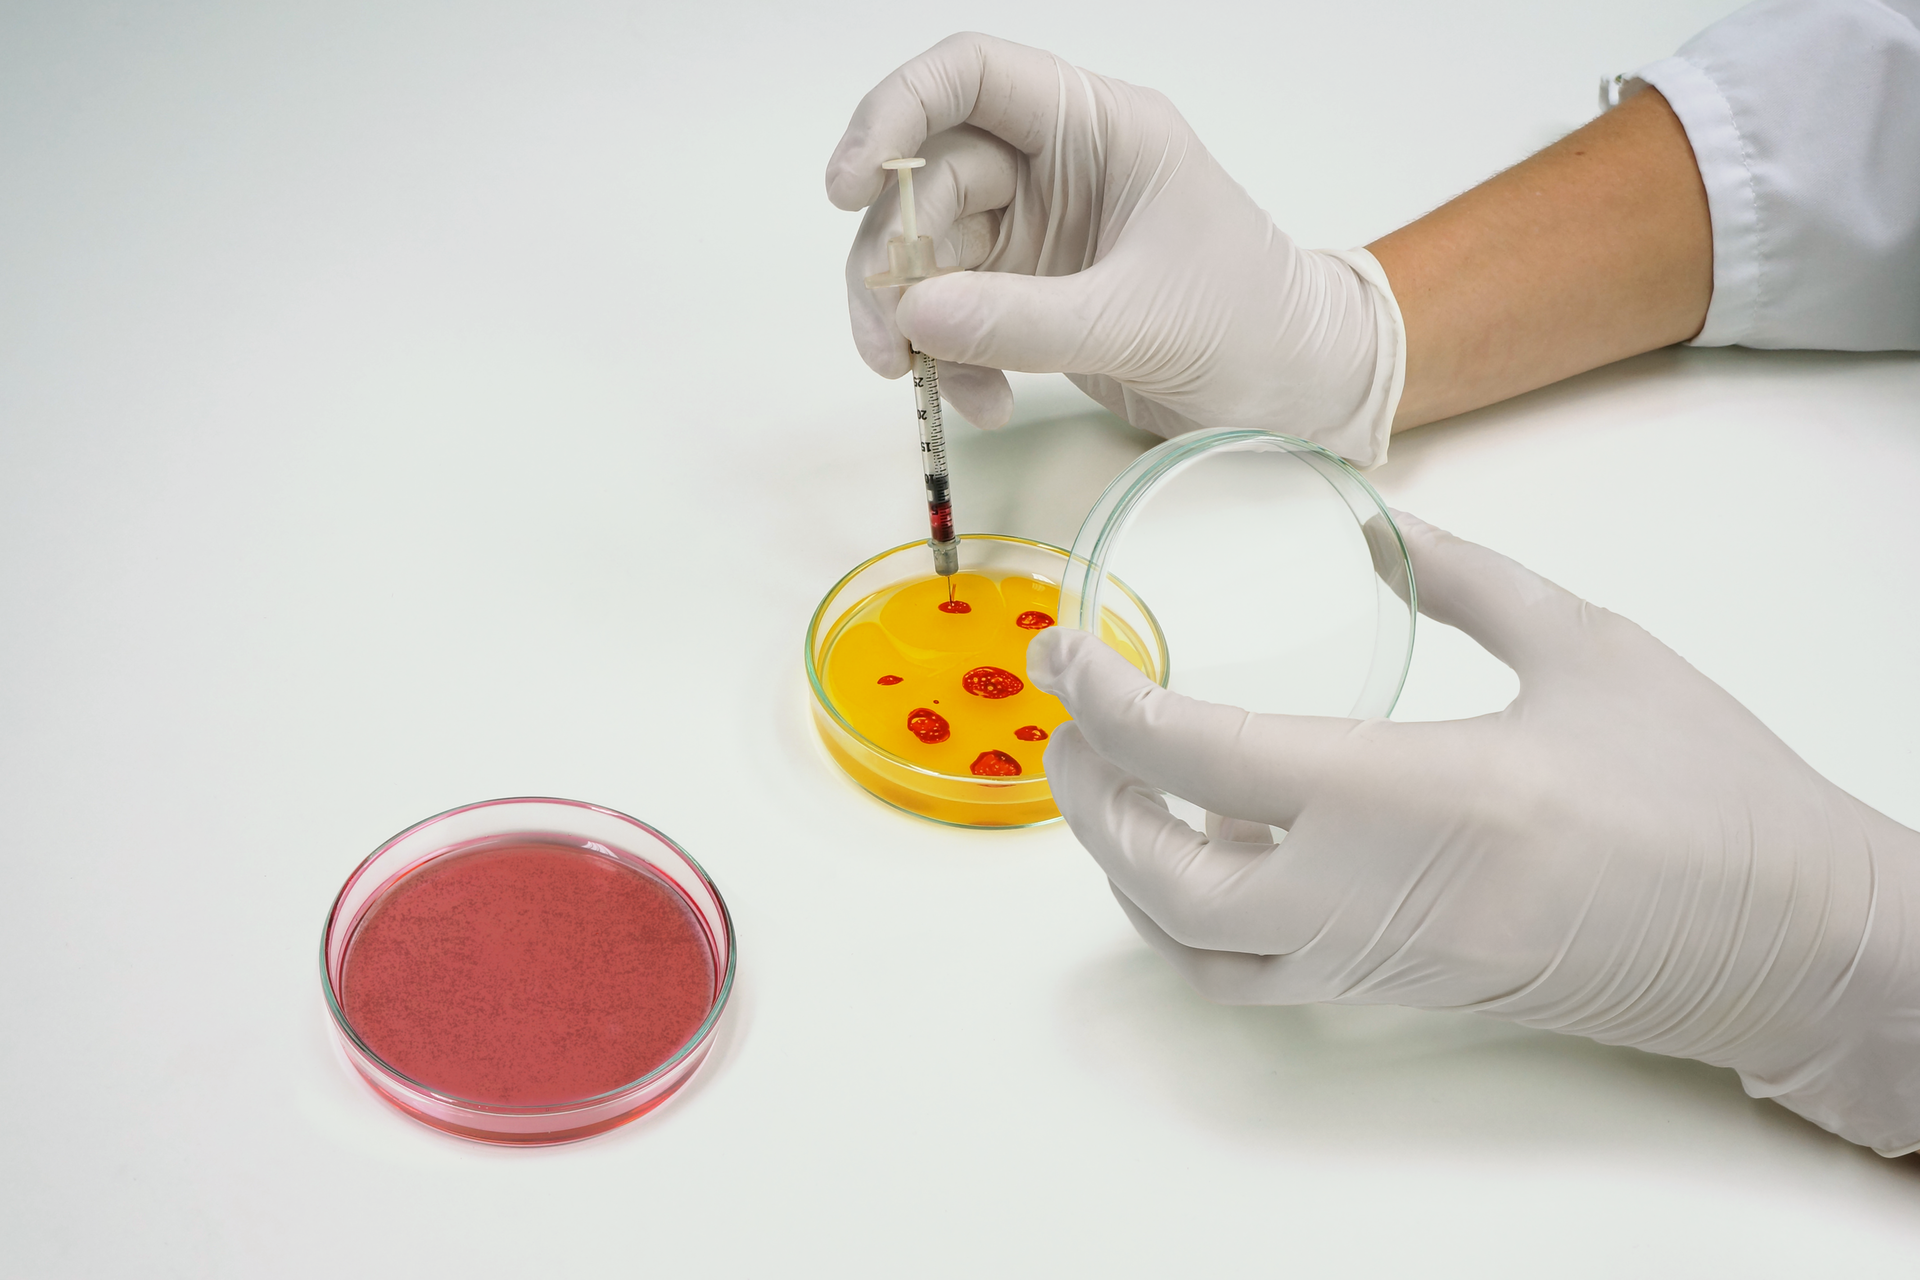
Zdjęcie przedstawia przykład inżynierii genetycznej. Laborant nakłada próbki na szalkę Petriego. Próbki są czerwone, a pożywka w szalce żółta. Widać dłonie laboranta, ma ubrane rękawiczki.

Oblicza biotechnologii
Poznanie budowy i właściwości DNA zapoczątkowało intensywny rozwój biotechnologii molekularnej. Jedną ze stosowanych w tej dziedzinie metod jest modyfikacja genów. Umożliwia ona tworzenie organizmów o cechach korzystnych dla człowieka albo środowiska. Jej osiągnięcia służą medycynie, sądownictwu, przemysłowi, rolnictwu i ochronie przyrody. Produkty biotechnologii niewątpliwie przynoszą pożytek, jednak budzą również obawy związane z ich możliwym negatywnym wpływem na środowisko i zdrowie człowieka oraz kontrowersje dotyczące ich etycznego wykorzystania.
co to jest DNA;
czym jest biotechnologia;
jak dzieli się biotechnologię;
jakie są zastosowania biotechnologii;
czym jest fermentacja oraz jak przebiega fermentacja alkoholowa i mlekowa.
Rozróżnisz biotechnologię tradycyjną i molekularną.
Przedstawisz współczesne zastosowania metod biotechnologii tradycyjnej w przemyśle farmaceutycznym, spożywczym, rolnictwie, biodegradacji i oczyszczaniu ścieków.
Przedstawisz istotę elektroforezy DNA, metody PCR, sekwencjonowania DNA.
Przedstawisz zastosowania wybranych technik inżynierii genetycznej w medycynie sądowej, kryminalistyce, diagnostyce chorób.
Wyjaśnisz, czym jest organizm transgeniczny i GMO. Przedstawisz sposoby otrzymywania organizmów transgenicznych.
Przedstawisz potencjalne korzyści i zagrożenia wynikające z zastosowania organizmów modyfikowanych genetycznie w rolnictwie, przemyśle, medycynie i badaniach naukowych.
Podasz przykłady produktów otrzymanych z wykorzystaniem modyfikowanych genetycznie organizmów.
Opiszesz klonowanie organizmów i przedstawisz znaczenie tego procesu.
Przedstawisz sposoby otrzymywania i pozyskiwania komórek macierzystych oraz ich zastosowania w medycynie.
Przedstawisz sytuacje, w których zasadne jest korzystanie z poradnictwa genetycznego.
Wyjaśnisz istotę terapii genowej.
Przedstawisz szanse i zagrożenia wynikające z zastosowań biotechnologii molekularnej.
Przeprowadzisz dyskusję o problemach społecznych i etycznych związanych z rozwojem inżynierii genetycznej oraz sformułujesz własną opinię w tym zakresie.
Zrealizujesz projekt filmowy o wykorzystaniu badań DNA w nauce, medycynie i sądownictwie.
1. Biotechnologia
Biotechnologia jest interdyscyplinarną nauką, która bada i opracowuje różne sposoby wykorzystania materiałów i procesów biologicznych na skalę przemysłową.
Więcej informacji o biotechnologii w e‑materiale Biotechnologia – nauka interdyscyplinarnaBiotechnologia – nauka interdyscyplinarna.
2. Zastosowania biotechnologii tradycyjnej
Dziedzina | Przykłady zastosowań |
|---|---|
Przemysł spożywczy | Produkcja m.in. kiszonych warzyw i owoców, serów podpuszczkowych i innych przetworów mlecznych, napojów alkoholowych, pieczywa i ciast drożdżowych |
Przemysł farmaceutyczny | Otrzymywanie biofarmaceutyków, m.in. antybiotyków (penicylina, streptomycyna), hormonów (insulina, ludzki hormon wzrostu) |
Rolnictwo | Sztuczna selekcja osobników o pożądanych cechach, produkcja biopestycydów oraz stymulatorów wzrostu i plonowania roślin |
Ochrona środowiska | Usuwanie skażeń gleb i wód, biologiczne oczyszczanie ścieków, produkcja biogazów i biopaliw, stosowanie biosensorów i polimerów biodegradowalnych |
Więcej informacji o biotechnologii tradycyjnej znajdziesz w e‑materiałach:
Biotechnologia tradycyjnaBiotechnologia tradycyjna;
Biotechnologia w ochronie środowiskaBiotechnologia w ochronie środowiska;
Metody biotechnologii tradycyjnejMetody biotechnologii tradycyjnej;
Zastosowania biotechnologii tradycyjnej w rolnictwie i ochronie środowiskaZastosowania biotechnologii tradycyjnej w rolnictwie i ochronie środowiska;
Zastosowania biotechnologii tradycyjnej w przemyśleZastosowania biotechnologii tradycyjnej w przemyśle.
3. Inżynieria genetyczna narzędziem biotechnologii molekularnej
Inżynieria genetyczna to zbiór technik dających możliwość zamierzonego i kontrolowanego wprowadzenia zmiany w genomie lub wprowadzenia genu pobranego z materiału genetycznego jednego organizmu do genomu innego organizmu.
Techniki stosowane w inżynierii genetycznej to:
łańcuchowa reakcja polimerazy (PCR), która polega na otrzymaniu dużej liczby kopii pożądanego odcinka DNA;
elektroforeza DNA, która polega na rozdzielaniu fragmentów DNA w zależności od ich wielkości;
sekwencjonowanie DNA, które umożliwia określanie kolejności nukleotydów we fragmencie DNA.
Projekt poznania ludzkiego genomu (HGP) zakończył się niewątpliwym sukcesem. Informacje uzyskane w wyniku jego realizacji mogą zostać wykorzystane w opracowaniu skuteczniejszych metod diagnozy chorób genetycznych oraz w wykrywaniu ryzyka ich wystąpienia.
Odpowiedz na pytania:
Jak twoim zdaniem wiedza na temat sekwencji DNA w genomie człowieka może być wykorzystywana dla dobra ludzkości?
Do kogo powinny należeć dane opracowane podczas projektu i kto powinien mieć do nich dostęp?
Czy chciałbyś/chciałabyś znać szczegóły swojego genomu?
Czy twoim zdaniem powinno się stworzyć bazę profili genetycznych wszystkich obywateli?
Dziedzina | Przykłady zastosowań |
|---|---|
Medycyna sądowa | Badania ojcostwa i pokrewieństwa, ustalanie tożsamości osób zmarłych |
Kryminalistyka | Ustalanie tożsamości przestępców i ofiar |
Diagnostyka chorób | Identyfikacja sekwencji DNA odpowiedzialnych za rozwój chorób genetycznych, wykrywanie DNA patogenu w próbce |
Więcej informacji o biotechnologii molekularnej znajdziesz w e‑materiałach:
Inżynieria genetyczna narzędziem biotechnologii – materiał wprowadzającyInżynieria genetyczna narzędziem biotechnologii – materiał wprowadzający;
Wykorzystanie badań DNA w medycynieWykorzystanie badań DNA w medycynie;
Wykorzystanie badań DNA w nauceWykorzystanie badań DNA w nauce;
Wykorzystanie badań DNA w sądownictwieWykorzystanie badań DNA w sądownictwie;
Biotechnologia molekularna – historia, cele i perspektywyBiotechnologia molekularna – historia, cele i perspektywy;
Enzymy stosowane w biotechnologii molekularnejEnzymy stosowane w biotechnologii molekularnej.
Więcej informacji o meodzie PCR znajdziesz w e‑materiale Łańcuchowa reakcja polimerazyŁańcuchowa reakcja polimerazy.
Więcej informacji o elektroforezie znajdziesz w e‑materiale Analiza restrykcyjna i elektroforeza DNAAnaliza restrykcyjna i elektroforeza DNA.
Więcej informacji o sekwencjonowaniu DNA i Projekcie poznania ludzkiego genomu znajdziesz w e‑materiałach:
Sekwencjonowanie DNASekwencjonowanie DNA;
Genom człowiekaGenom człowieka.
Organizmy modyfikowane genetycznie
Organizm modyfikowany genetycznie (GMO) to organizm, którego materiał genetyczny został zmieniony za pomocą technik inżynierii genetycznej. W wyniku modyfikacji genetycznych powstają mikroorganizmy, rośliny i zwierzęta o takich cechach, których otrzymanie poprzez dobór sztuczny trwałoby bardzo długo lub byłoby niemożliwe.
Więcej informacji o organizmach modyfikowanych genetycznie znajdziesz w e‑materiałach:
Mikroorganizmy zmodyfikowane genetycznie – cele i metody transformacjiMikroorganizmy zmodyfikowane genetycznie – cele i metody transformacji;
Wykorzystanie organizmów zmodyfikowanych genetycznie w badaniach podstawowychWykorzystanie organizmów zmodyfikowanych genetycznie w badaniach podstawowych;
Wykorzystanie organizmów zmodyfikowanych genetycznie w gospodarce człowiekaWykorzystanie organizmów zmodyfikowanych genetycznie w gospodarce człowieka;
Organizmy zmodyfikowane genetycznie – szansa czy zagrożenie?Organizmy zmodyfikowane genetycznie – szansa czy zagrożenie?
Klonowanie
Klonowanie polega na pozyskaniu genetycznych kopii organizmów, komórek lub cząsteczek DNA. Genetyczne kopie nazywane są klonami.
Klonowanie metodą transplantacji jąder komórkowych przebiega następująco:
Pobranie jądra komórkowego z komórki klonowanego osobnika.
Usunięcie jądra komórkowego z komórki jajowej uzyskanej od biorcy.
Połączenie jądra komórkowego klonowanego osobnika z
pustą
komórką jajową.Pobudzenie otrzymanej komórki do podziałów.
Wszczepienie zarodka do macicy matki zastępczej.
Urodzenie się klonu osobnika, od którego pobrano jądro komórkowe.
Więcej informacji o klonowaniu znajdziesz w e‑materiałach:
Klonowanie zwierzątKlonowanie zwierząt;
Fabryka zwierzątFabryka zwierząt;
Praktyczne wykorzystanie metod klonowania organizmówPraktyczne wykorzystanie metod klonowania organizmów;
Obawy etyczne wokół klonowania zwierzątObawy etyczne wokół klonowania zwierząt.
Komórki macierzyste
Komórki macierzyste to komórki mogące różnicować się w inne typy komórek.
Więcej informacji o komórkach macierzystych znajdziesz w e‑materiałach:
Otrzymywanie i pozyskiwanie komórek macierzystychOtrzymywanie i pozyskiwanie komórek macierzystych;
Zastosowanie komórek macierzystych w medycynieZastosowanie komórek macierzystych w medycynie;
Jak wyhodować wątrobę?Jak wyhodować wątrobę?;
Komórki macierzyste – szanse i zagrożeniaKomórki macierzyste – szanse i zagrożenia.
Terapia genowa
Terapia genowa jest metodą leczenia niektórych chorób genetycznych, polegającą na wprowadzeniu obcego DNA do komórek ciała pacjenta. Celem terapii może być:
dostarczenie do komórek pacjenta poprawnej wersji genu;
wyciszenie aktywności wadliwego genu;
skierowanie komórek na drogę apoptozy.
Więcej informacji o terapii genowej znajdziesz w e‑materiałach:
Terapia genowaTerapia genowa;
Procedura terapii genowejProcedura terapii genowej;
Terapia genowa i poradnictwo genetyczneTerapia genowa i poradnictwo genetyczne.
Poradnictwo genetyczne
Poradnictwo genetyczne ma na celu objęcie specjalistyczną pomocą osoby z chorobą genetyczną lub wrodzoną wadą rozwojową oraz jej rodziny. W poradni genetycznej można otrzymać informacje dotyczące sposobu dziedziczenia danej choroby, ryzyka wystąpienia tej choroby u dziecka oraz możliwej terapii osób chorych.
Więcej informacji o poradnictwie genetycznym znajdziesz w e‑materiale Poradnictwo genetycznePoradnictwo genetyczne.
Zadania



Na podstawie tekstu wykonaj polecenia.
Aby dokonać transformacji rośliny, trzeba najpierw wybrać i powielić gen, którym chcemy wzbogacić jej materiał genetyczny. Gen jest namnażany poza organizmem, z którego pochodzi, i wprowadzany do odpowiedniego wektora, np. bakterii Agrobacterium tumefaciens. Przygotowanie bakterii polega na usunięciu genów wywołujących chorobę rośliny i zastąpienie ich wybranym celowo fragmentem DNA (transgenem). Tak zmodyfikowane bakterie są namnażane. Na kolejnym etapie przygotowuje się tkankę roślinną. Mogą to być liście, wierzchołki wzrostu, zarodki, które zostają zranione, by ułatwić wnikanie bakterii. Gdy bakteria zainfekuje komórki roślinne, transgen powinien zostać wbudowany w ich genomy. By potwierdzić, czy do tego doszło, wykonuje się następujące czynności:
poddane transformacji tkanki hoduje się na pożywce, która ogranicza wzrost niezmienionych genetycznie komórek;
z wyselekcjonowanych tkanek odtwarza się rośliny in vitro (w warunkach laboratoryjnych, poza organizmem);
prowadzi się badania potwierdzające, że otrzymane w ten sposób rośliny zawierają wprowadzone sztucznie geny i produkują zakodowane przez nie białka, a także że w hodowli nie występuje A. tumefaciens;
prowadzi się polową uprawę sadzonek i obserwuje m.in., czy gen został wbudowany na stałe, czy produkcja białka zachodzi w oczekiwany sposób oraz czy wprowadzony gen nie wywołuje niepożądanych zmian.
Przedstaw kolejne czynności, jakie wykonuje badacz w celu uzyskania zmodyfikowanej rośliny.
Określ, co jest wektorem genetycznym zastosowanym w opisanej transformacji.
Projekt badawczy
Festiwal filmów „DNA w nauce, medycynie i sądownictwie”
Na podstawie podręcznika i informacji z innych źródeł zilustrujcie wykorzystanie badań DNA w jednej z wybranych dziedzin: nauka, medycyna lub sądownictwo.
Dobierzcie zespół realizujący film.
Opracujcie scenariusz filmu.
Wybierzcie dowolny gatunek filmu, może to być film fabularny, dokumentalny albo animacja.
Nadajcie mu ciekawy tytuł.
Opiszcie kilka scen, wykorzystując poradnik Jak napisać scenariusz filmowy? ze strony Edukacja Filmowa.
Zrealizujcie film z wykorzystaniem telefonu komórkowego, tabletu lub kamery filmowej.
W karcie pracy zanotuj swoje refleksje. Odpowiedz na pytania:
Jaki jest cel filmu?
Co i w jaki sposób chcesz w nim pokazać?
Kto ma być odbiorcą filmu?
Jak zaciekawić widza?
Gdzie znajdziesz potrzebne informacje?
Kogo zaprosisz do realizacji filmu; kto będzie liderem projektu filmowego, reżyserem, scenografem, aktorem, wizażystą, operatorem, montażystą, dźwiękowcem?